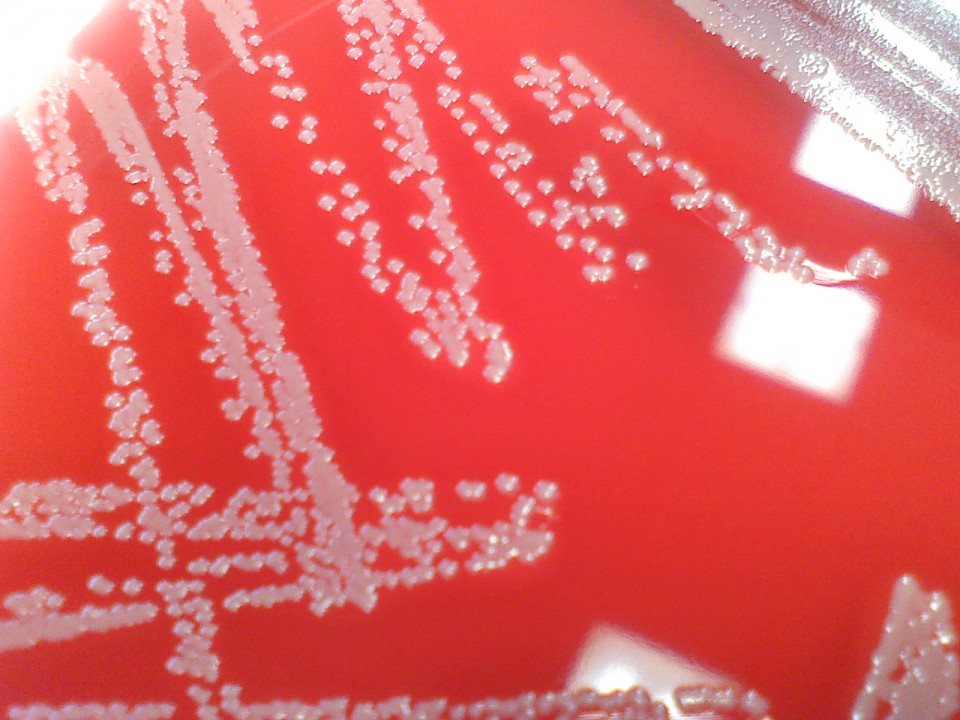
phat hien chat khang sinh cuc manh trong mui nguoi

| TIN LIÊN QUAN | |
| Phát hiện kháng thể để sản xuất vaccine phòng virus Zika | |
| Vaccine cúm có thể hỗ trợ cho bệnh nhân đái tháo đường | |
Theo kết quả nghiên cứu được đăng tải trên tạp chí Nature (Mỹ) ngày 28/7, vi khuẩn được tìm thấy ở mũi người có tên gọi Staphylococcus lugdunensis. Nó có khả năng sản sinh ra chất hugdunin, một loại kháng sinh chống lại phần lớn mầm bệnh.
![]() |
| Mẫu vi khuẩn Staphylococcus lugdunensis. (Nguồn: The Retroscope) |
Các nhà nghiên cứu thuộc Đại học Tubingen ở Đức cho biết, đặc tính của chất này là nó không làm gia tăng hiện tượng kháng thuốc ở những loài vi khuẩn mà nó nhắm đến tiêu diệt do việc sử dụng thuốc kháng sinh nhiều lần.
Năm 2009, lần đầu tiên giới khoa học đã phát hiện "siêu khuẩn" gene NDM-1 ở Ấn Độ. Đây là siêu khuẩn đa kháng sinh bởi lẽ chúng có khả năng đề kháng với tất cả các loại thuốc kháng sinh hiện có. Theo truyền hình CNN (Mỹ), mỗi năm siêu khuẩn này là nguyên nhân của khoảng 700.000 ca tử vong trên thế giới.
Phát hiện mới trên mở ra triển vọng sản xuất các loại thuốc kháng sinh có thể tiêu diệt siêu khuẩn nói trên, song một số chuyên gia cho rằng, việc lấy chất kháng sinh trong mũi người sẽ khó phục vụ mục đích thương mại, bởi việc làm này có thể gây hại cho tế bào của người.
| Thuốc chữa sốt rét có thể hỗ trợ điều trị ung thư Mới đây, các nhà khoa học Anh đã phát hiện được rằng, thuốc chữa sốt rét Atovaquone có thể hỗ trợ điều trị ung thư. |
| Rượu có thể gây ra 7 loại ung thư Các nhà khoa học New Zealand vừa chỉ ra rằng, uống rượu không chỉ gây ung thư gan mà còn gây ra 6 loại ung ... |
| Hạt nano silicon mang theo thuốc điều trị ung thư Hạt nano này có đủ sức đưa thuốc vào các khối u, đồng thời phân hủy nhanh chóng thành acid silicic và một số phân ... |